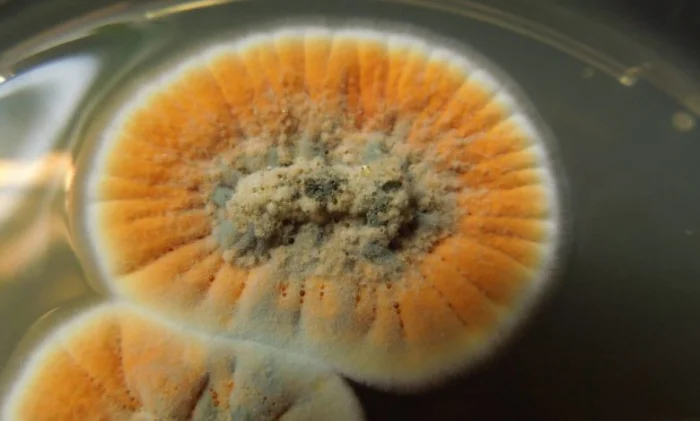

История спасения: как случайная плесень изменила мир медицины
У тебя когда-нибудь было сильное воспаление горла? А может, мучила ушная инфекция? Сегодня мы на такие проблемы часто даже внимания не обращаем — выпил таблетку, и порядок. Но ещё каких-то сто лет назад любой порез мог отправить человека в могилу. Что же случилось? Мы нашли способ приручить плесень. И речь, конечно, о пенициллине.
3 сентября 1928 года Александр Флеминг сидел в своей лаборатории и, как обычно, изучал бактерии. Работа не пыльная, но кропотливая. И вдруг он замечает на одной из чашек Петри плесень. Ну плесень и плесень, выбросить и забыть. Но Флеминг присмотрелся и обомлел: вокруг пятен плесени бактерии не росли. Они словно боялись этого пушистого захватчика. Оказалось, плесень принадлежала к роду Пеницилл. Так началась эра антибиотиков.
Флеминг сначала назвал своё открытие «грибным соком» (звучит не очень аппетитно, правда?), а потом переименовал в пенициллин. Но в одиночку справиться с производством лекарства было сложно. К делу подключилась команда из Оксфорда: Говард Флори, Эрнст Чейн и Норман Хитли. Они научились выделять и очищать пенициллин. И тут — первый пациент.
Альберт Александр, полицейский с тяжелейшей инфекцией, получил дозу нового препарата и пошёл на поправку. Но лекарства хватило не надолго. Когда запас кончился, инфекция вернулась, и Альберт умер. Трагедия, но она дала бесценный урок: пенициллин работает, нужно просто научиться производить его в промышленных масштабах.
Флори и Чейн улетели в США, где нашли способы быстро выращивать плесень в огромных чанах. Уже к 1942 году пенициллин начали применять для лечения раненых солдат Второй мировой. Цифры говорят сами за себя: в Первую мировую бактериальная пневмония убила 18% американских военных, а во Вторую — меньше 1%. Лекарство из плесени спасло миллионы.
Сегодня антибиотики — привычная часть нашей жизни. Но врачи всё чаще бьют тревогу: бактерии учатся сопротивляться, появляются супербактерии. Именно поэтому нельзя пить антибиотики без назначения — мы сами помогаем микробам становиться сильнее. А вдруг скоро появится новый Флеминг, который найдёт способ победить рак или болезнь Альцгеймера? Кто знает, может, это будешь ты.